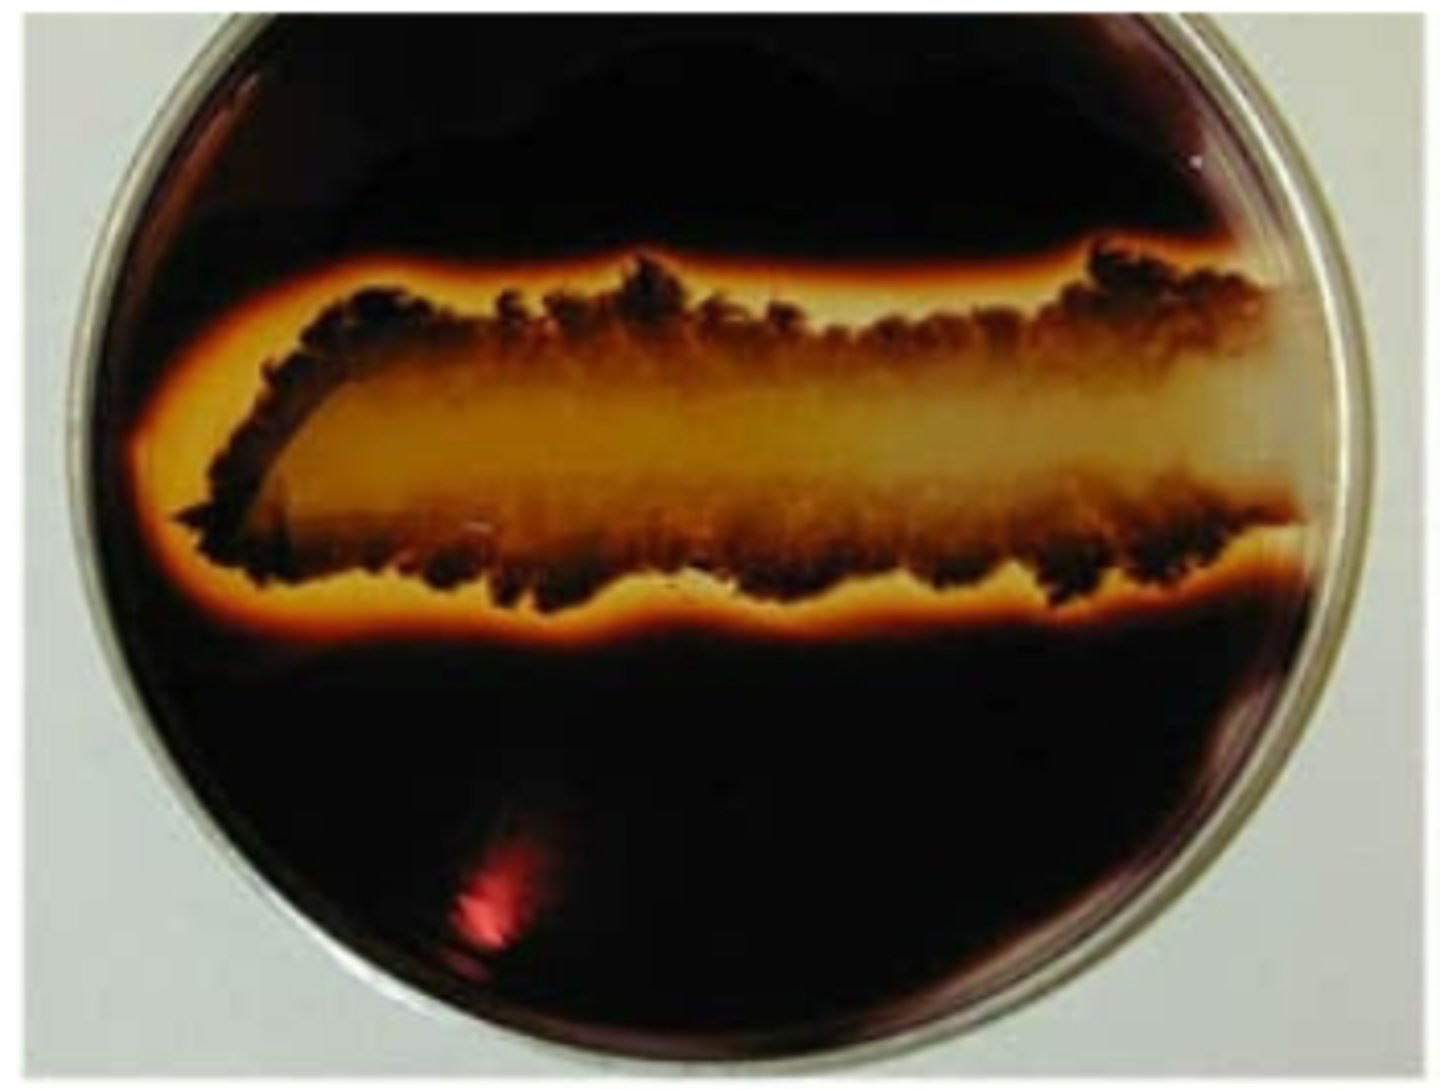
<p>Does this bacteria produce amylase or is there starch present?</p>

1/228
Looks like no tags are added yet.
Name | Mastery | Learn | Test | Matching | Spaced |
|---|
No study sessions yet.
seta (moss)
Name the blank REPRODUCTIVE STRUCTURE

pores that regulate gas exchange
stomata
open and close stomata based on level of water stress
Guard Cell
stomata (leaf peel)
What is the BLANK structure?

guard cells (leaf peel)
What is the BLANK structure?

antheridiophore (liverwort)
What REPRODUCTIVE STRUCTURE is this?

spherical
Shape of bacteria: Cocci
rod-shaped
Shape of bacteria: Bacilli
spiral-shaped (corkscrew)
Shape of bacteria: Spirilla
Cocci
Which Bacteria is this? (shape)

Bactilli
Which Bacteria is this? (shape)

Spirillium
Which Bacteria is this? (shape)

dark purple
Gram-Positive Stain Color
pink
Gram-Negative Stain Color
the bacteria has a thick peptidoglycan layer in cell walls
What does a Gram-Positive stain indicate?
the bacteria has a thin peptidoglycan layer in cell walls
What does a Gram-Negative stain indicate?
Clear halo = amylase
Does this bacteria produce amylase or is there starch present?
Dark (purple) halo = no amylase, starch present
Does this bacteria produce amylase or is there starch present?

fixes nitrogen
Heterocyst
heterocyst
What is the arrow pointing to?

Cyanobacteria
What is the PHYLUM of the organism pictured?

Anabaena
What is the GENUS of the organism pictured?

Cyanobacteria
What is the PHYLUM of the organism pictured?

Oscillatoria
What is the GENUS of the organism pictured?

Archaea
Archaea - facts x1
*Thermophiles
*Halophiles
*Methanogens
3 types of Archaea
Inhabit extremes of temperatures
Thermophile
Inhabit extremely salty areas
Halophile
Thrive in methane producing places
Methanogen
phagocytosis
How does an amoeba INGEST nutrients?
pseudopodia
How does the organism pictured FEED/MOVE?

Amoeba Proteus
What is the GENUS of the organism pictured?

Rhizopoda
What is the PHYLUM of the organism pictured?

when a cell uses its plasma membrane to ingest or engulf other cells or particles
Phagocytosis
Slime mold, NOT fungus
Physarum is a type of BLANK, not a BLANK
single large cell, multiple nuclei
Physarum has ONE or MORE THAN ONE nuclei?
amoeboid movement
How does the organism pictured MOVE?

Myxogastrida
What is the PHYLUM of the organism pictured?

Physarum
What is the GENUS of the organism pictured?

Amoebozoa
What is the LINEAGE of the organism pictured?

Termite symbionts in gut
Trichonympha
Trichonympha
What is the GENUS of the organism pictured?

Parabasalida
What is the PHYLUM of the organism pictured?

Excavata
What is the LINEAGE of the organism pictured?

Amoebozoa
What is the LINEAGE of the organism pictured?

sexually transmitted disease
Trichomonas vaginalis
Trichomonas vaginalis
What is the GENUS of the organism pictured?

parabasalida
What is the PHYLUM of the organism pictured?

Excavata
What is the LINEAGE of the organism pictured?

african sleeping sickness
Trypanosoma brucei
Outside of blood cells
Does Typanosoma Brucci reside INSIDE or OUTSIDE blood cells?
Kinetoplastids
What is the PHYLUM of the organism pictured?

Excavata
What is the LINEAGE of the organism pictured?

Trypanosoma brucei
What is the GENUS of the organism pictured?

flagellar movement
How does the organism pictured MOVE?

Tsetse fly
What is the VECTOR of the organism pictured?

Amoeboid movement
How do Radiolarians MOVE?
Elaborate mineral skeleton (usually silica)
What gives Radiolarians their BODY STRUCTURE?
Axopodia (Pseudopodia)
What STRUCTURE do Radiolarans FEED with?
Rhizaria
What is the LINEAGE of the organism pictured?

Actinopoda
What is the PHYLUM of the organism pictured?

Radiolaria
What is the GENUS of the organism pictured?

Calcium shells (look like seashells)
What gives Forams their BODY STRUCTURE?
Amoeboid movement
How do Forams MOVE?
Pseudopodia
How do Forams FEED?
Foraminafera
What is the GENUS of this organism?

Rhizaria
What is the LINEAGE of this organism?

Foraminafera
What is the PHYLUM of this organism?

Inside blood cells
Does Plasmodium vivax reside INSIDE or OUTSIDE blood cells?
Malaria
What DISEASE is caused by Plasmodium vivax?
mosquitos
What is the VECTOR for this organism?

malaria
What DISEASE is caused by this organism?

Apicomplexa
What is the PHYLUM of this organism?

Plasmodium vivax
What is the GENUS of this organism?

Alveolata
What is the LINEAGE of this organism?

cilia
How does this organism MOVE/FEED?

Alveolata
What is the LINEAGE of this organism?

Paramecium
What is the GENUS of this organism?

Ciliata
What is the PHYLUM of this organism?

Alveolata
What is the LINEAGE of this organism?

Ciliata
What is the PHYLUM of this organism?

Euplotes
What is the GENUS of this organism?

cillia called cirri
How does this organism MOVE?

Spring-like movement
What does Vorticella MOVE LIKE?
vortices
What is the DEFINING FEATURE of Vorticella (gives it's name)?
cilia
How does this organism FEED?

vorticella
What is the GENUS of this organism?

Alveolata
What is the LINEAGE of this organism?

Ciliata
What is the PHYLUM of this organism?

Cellulose (rather than chitin)
What gives Achyla its BODY STRUCTURE?
Multiple nuclei
Does Achyla have ONE or MULTIPLE nuclei?
Water mold, not a fungus
Achlya is a BLANK not a type of BLANK
Plant and animals
Achlya is a PATHOGEN to whomn?
Achlya
What is the GENUS of this organism?

Oomycota
What is the PHYLUM of this organism?

Stramenopila
What is the LINEAGE of this organism?

Photosynthetic eukaryotes
What is Algae DEFINED as (classifications)?
Euglena
What is the GENUS of this organism?

Euglenida
What is the PHYLUM of this organism?

Excavata
What is the LINEAGE of this organism?
